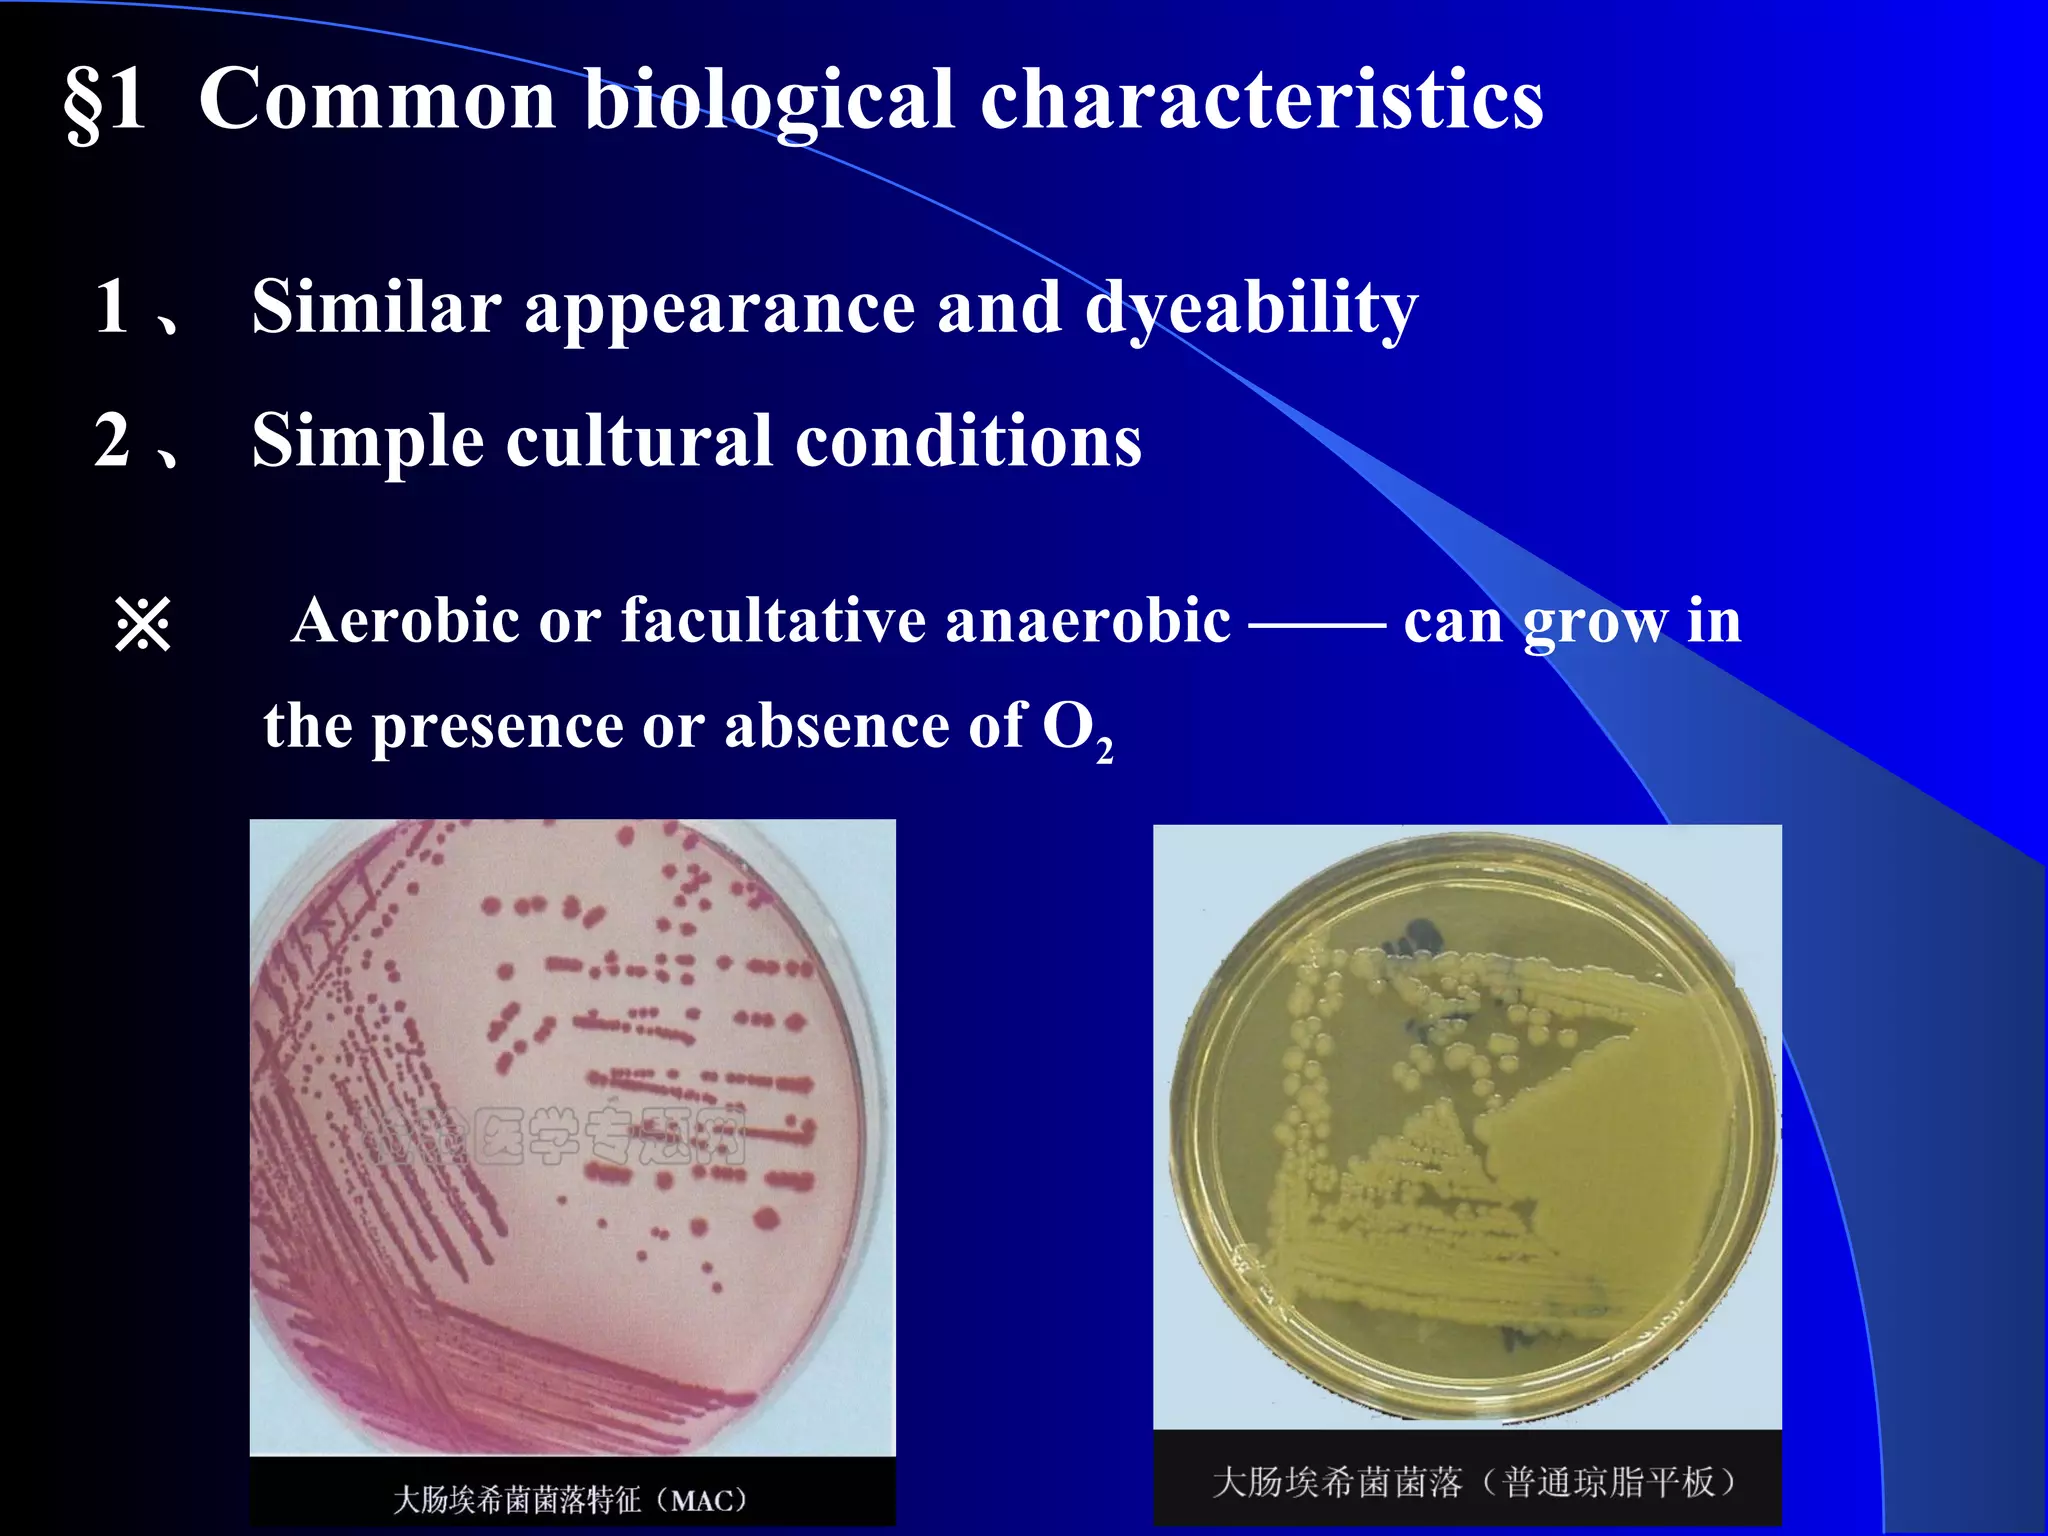
§1 Common biological characteristics
1 、 Similar appearance and dyeability
2 、 Simple cultural conditions
※ 　 Aerobic or facultative anaerobic —— can grow in
the presence or absence of O2

1. Enterobacteriaceae are a family of Gram-negative, non-spore forming rods that are normal flora of the gastrointestinal tract. They include many important pathogens like Escherichia, Salmonella, Shigella.
2. They are facultative anaerobes that ferment glucose and reduce nitrates. Identification is based on lactose fermentation and reactions on selective media.
3. Shigella causes bacillary dysentery. It is non-motile and invades the colonic epithelium, causing severe diarrhea, fever and tenesmus. Virulence factors include invasion plasmid antigens.


![※ Lactose fermentation: normal flora ( + ) and
pathogens
( - ) .
※ Primary isolation media include eosin ['i əs n]-methylene-ː ɪ
blue (EMB) and MacConkey agar.
※ Differential selective media for specific organisms
including dyes and bile salts. (Salmonella-Shigella (SS)
medium, bismuth ['b zməθ]sulfite media.)ɪ](https://image.slidesharecdn.com/10-enterobacteriaceae-150727150858-lva1-app6891/75/10-enterobacteriaceae-3-2048.jpg)

![Stxlysogenic phage
intestinal villi( ['v li ]ɪ ː 绒毛)
kindey epithelial cells
Gb3(glycolipid receptor)
Split 28S rRNA in 60S subunit
Termination of host protein synthesis
Upregulation gene
expression of
inflammatory
factor
The pathogenic mechanisms of shiga(-type) toxins
Cell death
villus](https://image.slidesharecdn.com/10-enterobacteriaceae-150727150858-lva1-app6891/75/10-enterobacteriaceae-27-2048.jpg)









](https://image.slidesharecdn.com/10-enterobacteriaceae-150727150858-lva1-app6891/75/10-enterobacteriaceae-37-2048.jpg)













![Shigella
里急后重
结肠炎
[t 'nezməs]ɪ](https://image.slidesharecdn.com/10-enterobacteriaceae-150727150858-lva1-app6891/75/10-enterobacteriaceae-51-2048.jpg)





















![Salmonella — Clinical Manifestations
▲ severe systemic form, may be fatal
▲ The best studied enteric fever is typhoid fever
▲ may be preceded by gastroenteritis
▲ an incubation period of 10 to 14 days
▲ symptoms of enteric fevers are nonspecific:fever,
anorexia[ ænə'reksiə] (ˌ 厌食症) , headache, myalgias, and
constipation (便秘)
3) Enteric fevers — typhoid3) Enteric fevers — typhoid](https://image.slidesharecdn.com/10-enterobacteriaceae-150727150858-lva1-app6891/75/10-enterobacteriaceae-73-2048.jpg)
![Salmonella — Clinical Manifestations
3) Enteric fevers — typhoid3) Enteric fevers — typhoid
★ primary bacteraemic phase:
(7- 10 days of the incubation period )
▲ invade the epithelium
▲ spread to mesenteric [mesən'ter k]ɪ (肠系膜
的) lymph
nodes & throughout the body
▲ be taken up by the reticuloendothelial cells (网状内皮细胞)
△ infect the liver, spleen, gallbladder, bones, meninges
[mə'n nd i z]ɪ ʒ ː](https://image.slidesharecdn.com/10-enterobacteriaceae-150727150858-lva1-app6891/75/10-enterobacteriaceae-74-2048.jpg)

![Salmonella — Clinical Manifestations
3) Enteric fevers — typhoid3) Enteric fevers — typhoid
▲ Onset: 2 weeks/ insidious/early symptoms
▲ Progression :
the temperature shows a stepladder rise over the 1st week of the
illness, remains high for 7-10 days and then falls by lysis during
the 3rd or 4th week.
physical signs include a relative bradycardia [bræd 'k d ə]ɪ ɑː ɪ
(心搏徐缓 ) , hepatomegaly, splenomegaly ( 肝脾肿
大) and often a rash of rose spots.
▲ Relapse: shorter and milder.
▲ Complications: severe intestinal haemorrhage and perforation](https://image.slidesharecdn.com/10-enterobacteriaceae-150727150858-lva1-app6891/75/10-enterobacteriaceae-76-2048.jpg)







